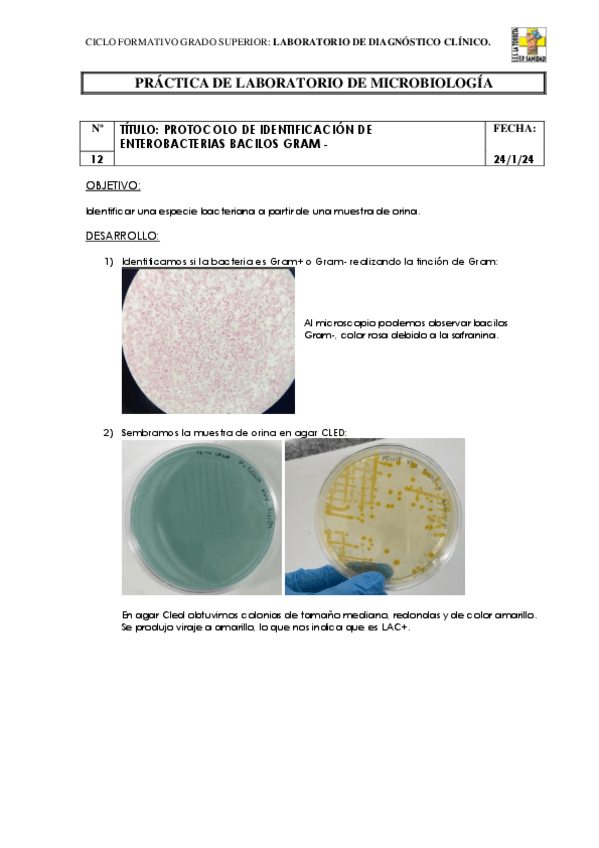

@Nuria3112
Bio:
104 Publicaciones
756 Interacciones
6 Seguidores
1 Siguiendo
Lista de publicaciones de Nuria3112
practicas
-
practicas gestion
He publicado nuevos practicas de Gestión de Muestras Biológicas: practicas gestion
practicas
-
Practicas hema
He publicado nuevos practicas de Técnicas de análisis hematológico: Practicas hema
practicas
-
Practicas inmuno
He publicado nuevos practicas de Técnicas de inmunodiagnóstico: Practicas inmuno
practicas
-
Practicas micro
He publicado nuevos practicas de Microbiología Clínica: Practicas micro